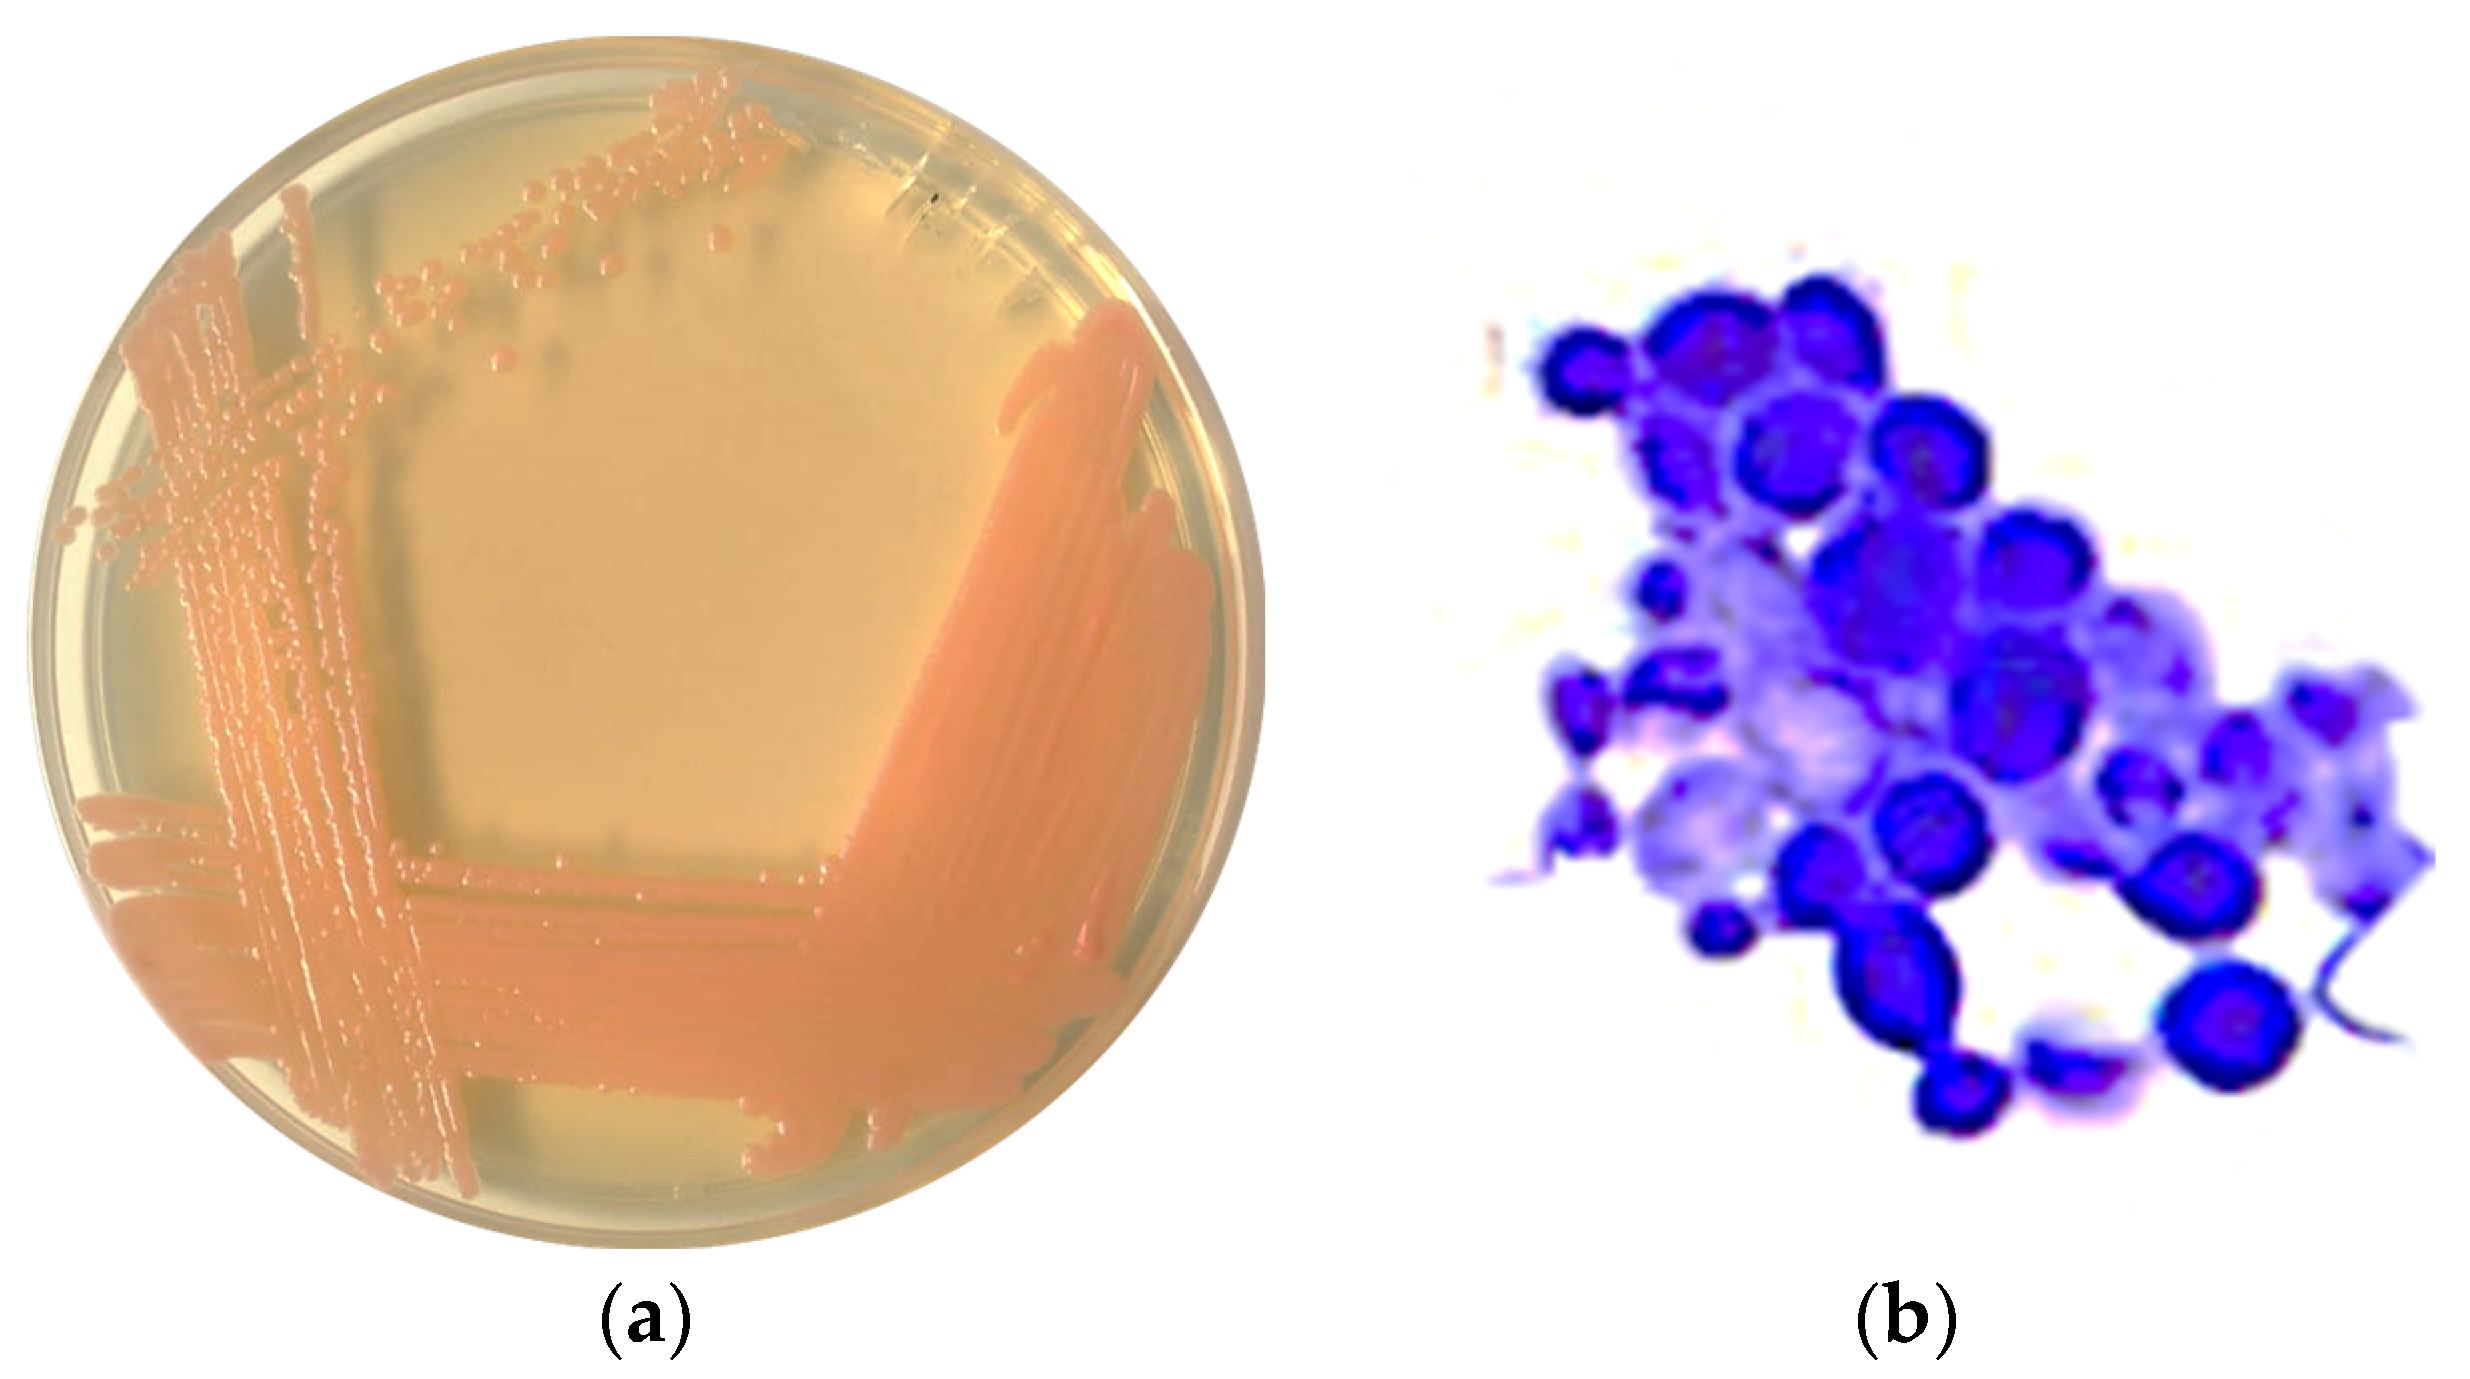

Bioremediation with an Alkali-Tolerant Yeast of Wastewater (Nejayote) Derived from the Nixtamalization of Maize
Abstract
1. Introduction
2. Materials and Methods
2.1. Obtaining and Characterizing Nejayote
2.2. Culture Media
2.3. Isolation of Microorganisms and Pre-Selection of the Most Effective Ones
2.4. Choosing the Most Promising Microorganism
2.5. Kinetic Characterization of the Best Microorganism
2.6. Molecular Identification
2.7. Analytical Techniques
2.8. Statistical Analysis and Software
3. Results and Discussion
3.1. Physicochemical Composition of Nejayote
3.2. Isolation and Selection of the Microorganism
3.3. Identification of the LCRE Strain
3.4. Kinetic Characterization of Rhodotorula mucilaginosa LCRE in NEM
4. Conclusions
Supplementary Materials
Author Contributions
Funding
Institutional Review Board Statement
Informed Consent Statement
Data Availability Statement
Acknowledgments
Conflicts of Interest
References
- Mariscal Moreno, R.M.; Figueroa, J.D.C.; Santiago-Ramos, D.; Villa, G.A.; Sandoval, S.J.; Rayas-Duarte, P.; Véles-Medina, J.J.; Martínez Flores, H.E. The Effect of Different Nixtamalisation Processes on Some Physicochemical Properties, Nutritional Composition and Glycemic Index. J. Cereal Sci. 2015, 65, 140–146. [Google Scholar] [CrossRef]
- Méndez-Montealvo, G.; Solorza-Feria, J.; García-Suárez, F.; Bello-Pérez, L.A. Rheological Changes in Nixtamalised Maize Starch. J. Cent. South Univ. Technol. 2007, 14, 518–521. [Google Scholar] [CrossRef]
- Schaarschmidt, S.; Fauhl-Hassek, C. Mycotoxins during the Processes of Nixtamalization and Tortilla Production. Toxins 2019, 11, 227. [Google Scholar] [CrossRef] [PubMed]
- Meraz, K.A.S.; Vargas, S.M.P.; Maldonado, J.T.L.; Bravo, J.M.C.; Guzman, M.T.O.; Maldonado, E.A.L. Eco-Friendly Innovation for Nejayote Coagulation–Flocculation Process Using Chitosan: Evaluation through Zeta Potential Measurements. Chem. Eng. J. 2016, 284, 536–542. [Google Scholar] [CrossRef]
- Balderas-López, J.M.; Prinyawiwatkul, W.; Arámbula-Villa, G.; Hernández-Rosas, F.; Leyva-Ovalle, O.R.; Houbron, E.P.; Herrera-Corredor, J.A. Prevention of the Development of Polluting Characteristics in Cooking Water Residue from Nixtamalisation of Corn by Removing Solid Lime Particles. Int. J. Food Sci. Technol. 2019, 54, 705–714. [Google Scholar] [CrossRef]
- Acosta-Estrada, B.A.; Lazo-Vélez, M.A.; Nava-Valdez, Y.; Gutiérrez-Uribe, J.A.; Serna-Saldívar, S.O. Improvement of Dietary Fiber, Ferulic Acid and Calcium Contents in Pan Bread Enriched with Nejayote Food Additive from White Maize (Zea mays). J. Cereal Sci. 2014, 60, 264–269. [Google Scholar] [CrossRef]
- Salmerón-Alcocer, A.; Rodríguez-Mendoza, N.; Pineda-Santiago, V.; Cristiani-Urbina, E.; Juárez-Ramírez, C.; Ruiz-Ordaz, N.; Galíndez-Mayer, J. Aerobic Treatment of Maize-Processing Wastewater (Nejayote) in a Single-Stream Multi-Stage Bioreactor. J. Environ. Eng. Sci. 2003, 2, 401–406. [Google Scholar] [CrossRef]
- Valderrama-Bravo, C.; Gutiérrez-Cortez, E.; Contreras-Padilla, M.; Rojas-Molina, I.; Mosquera, J.C.; Rojas-Molina, A.; Beristain, F.; Rodríguez-García, M.E. Constant Pressure Filtration of Lime Water (Nejayote) Used to Cook Kernels in Maize Processing. J. Food Eng. 2012, 110, 478–486. [Google Scholar] [CrossRef]
- González-Martinez, S. Biological Treatability of the Wastewaters from the Alkaline Cooking of Maize (Indian Corn). Environ. Technol. Lett. 1984, 5, 365–372. [Google Scholar] [CrossRef]
- Castro-Muñoz, R.; Yáñez-Fernández, J. Valorization of Nixtamalization Wastewaters (Nejayote) by Integrated Membrane Process. Food Bioprod. Process. 2015, 95, 7–18. [Google Scholar] [CrossRef]
- Secretaría de Medio Ambiente y Recursos Naturales. Norma Oficial Mexicana NOM-001-SEMARNAT-2021. Límites Permisibles de Contaminantes En Las Descargas de Aguas Residuales En Cuerpos Receptores Propiedad de La Nación. In Diario Oficial de la Federación; SEMARNAT: Ciudad de México, México, 2022. [Google Scholar]
- Secretaría de Medio Ambiente, Recursos Naturales y Pesca. Norma Oficial Mexicana NOM-002-ECOL-1996. Límites Máximos Permisibles de Contaminantes En Las Descargas de Aguas Residuales a Los Sistemas de Alcantarillado Urbano o Municipal. In Diario Oficial de la Federación; SEMARNAP: Ciudad de México, México, 1998. [Google Scholar]
- Ramírez-Jiménez, A.K.; Castro-Muñoz, R. Emerging Techniques Assisting Nixtamalization Products and By-Products Processing: An Overview. Crit. Rev. Food Sci. Nutr. 2021, 61, 3407–3420. [Google Scholar] [CrossRef] [PubMed]
- Villela-Castrejón, J.; Acosta-Estrada, B.A.; Gutiérrez-Uribe, J.A. Microencapsulation of corn wastewater (nejayote) phytochemicals by spray drying and their release under simulated gastrointestinal digestion. J. Food Sci. 2017, 82, 1726–1734. [Google Scholar] [CrossRef] [PubMed]
- Buitimea-Cantúa, N.E.; Antunes-Ricardo, M.; Gutiérrez-Uribe, J.A.; del Refugio Rocha-Pizaña, M.; de la Rosa-Millán, J.; Torres-Chávez, P.I. Protein-Phenolic Aggregates with Anti-Inflammatory Activity Recovered from Maize Nixtamalization Wastewaters (Nejayote). LWT 2020, 134, 109881. [Google Scholar] [CrossRef]
- Dominguez-Hernandez, M.E.; Zepeda-Bautista, R.; Dominguez-Hernandez, E.; Valderrama-Bravo, M.D.C.; Hernández-Simón, L.M. Effect of Lime Water—Manure Organic Fertilizers on the Productivity, Energy Efficiency and Profitability of Rainfed Maize Production. Arch. Agron. Soil. Sci. 2020, 66, 370–385. [Google Scholar] [CrossRef]
- Téllez-Pérez, V.; López-Olguín, J.F.; Aragón, A.; Zayas-Pérez, M.T.; Téllez-Pérez, V.; López-Olguín, J.F.; Aragón, A.; Zayas-Pérez, M.T. Lodos residuales de nejayote como sustratos para la germinación de semillas de maíz azúl criollo. Rev. Int. Contam. Ambient. 2018, 34, 395–404. [Google Scholar] [CrossRef]
- López-Pacheco, I.Y.; Carrillo-Nieves, D.; Salinas-Salazar, C.; Silva-Núñez, A.; Arévalo-Gallegos, A.; Barceló, D.; Afewerki, S.; Iqbal, H.M.N.; Parra-Saldívar, R. Combination of Nejayote and Swine Wastewater as a Medium for Arthrospira maxima and Chlorella vulgaris Production and Wastewater Treatment. Sci. Total Environ. 2019, 676, 356–367. [Google Scholar] [CrossRef] [PubMed]
- Pedroza-Islas, R.; Durán de Bazúa, C. Aerobic Treatment of Maize-Processing Wastewater in a 50-Liter Rotating Biological Reactor. Biol. Wastes 1990, 32, 17–27. [Google Scholar] [CrossRef]
- España-Gamboa, E.; Domínguez-Maldonado, J.A.; Tapia-Tussell, R.; Chale-Canul, J.S.; Alzate-Gaviria, L. Corn Industrial Wastewater (Nejayote): A Promising Substrate in Mexico for Methane Production in a Coupled System (APCR-UASB). Environ. Sci. Pollut. Res. 2018, 25, 712–722. [Google Scholar] [CrossRef] [PubMed]
- García-Depraect, O.; Gómez-Romero, J.; León-Becerril, E.; López-López, A. A Novel Biohydrogen Production Process: Co-Digestion of Vinasse and Nejayote as Complex Raw Substrates Using a Robust Inoculum. Int. J. Hydrogen Energy 2017, 42, 5820–5831. [Google Scholar] [CrossRef]
- Del Angel-Acosta, Y.A.; Alvarez, L.H.; Garcia-Reyes, R.B.; Carrillo-Reyes, J.; Garcia-Gonzalez, A.; Meza-Escalante, E.R. Co-Digestion of Corn (Nejayote) and Brewery Wastewater at Different Ratios and pH Conditions for Biohydrogen Production. Int. J. Hydrogen Energy 2021, 46, 27422–27430. [Google Scholar] [CrossRef]
- Campos-Flores, R.C.; Reyna-Gómez, L.M.; Suárez-Vázquez, S.I.; Robledo-Olivo, A.; Cruz-López, A. Effect of Inoculum Pretreatment and Operational Mode of Reactor on BioH2 Production from Nixtamalization (Nejayote) and Abattoir Wastewater. Waste Biomass Valor. 2023, 15, 2145–2158. [Google Scholar] [CrossRef]
- Asaff Torres, A.J.; Reyes Vidal, M.Y. Method and System for the Integral Treatment of Wastewater from the Maize Industry. U.S. Patent 20150368138, 24 December 2015. [Google Scholar]
- García-Zamora, J.L.; Sánchez-González, M.; Lozano, J.A.; Jáuregui, J.; Zayas, T.; Santacruz, V.; Hernández, F.; Torres, E. Enzymatic Treatment of Wastewater from the Corn Tortilla Industry Using Chitosan as an Adsorbent Reduces the Chemical Oxygen Demand and Ferulic Acid Content. Process Biochem. 2015, 50, 125–133. [Google Scholar] [CrossRef]
- Contreras-Jácquez, V.; Virgo-Cruz, J.M.; García-Fajardo, J.; Obregón-Solís, E.; Mateos-Díaz, J.C.; Asaff-Torres, A. Pilot-Scale Nanofiltration Vibratory Shear Enhanced Processing (NF-VSEP) for the Improvement of the Separation and Concentration of Compounds of Biotechnological Interest from Tortilla Industry Wastewater (Nejayote). Sep. Purif. Technol. 2022, 300, 121921. [Google Scholar] [CrossRef]
- Valderrama-Bravo, C.; Fuentes-Prado, E.; Porras-Godínez, M.R.; Ramírez-Ortiz, M.E.; Reyna-Granados, M.A.; Gutiérrez-Cortez, E. Mechanical Separation of a Nixtamalization By-Product (Nejayote) and Scaling of Filtration Conditions from a Pilot Filter to a Press Filter of Higher Area. J. Food Eng. 2022, 328, 111058. [Google Scholar] [CrossRef]
- Ramírez, K.; Quintero-Soto, M.F.; Rochín-Medina, J.J. Enhancement of the Antioxidant and Antimicrobial Activities of Maize Wastewater by an Eco-Friendly Process. J. Food Meas. Charact. 2020, 14, 1682–1689. [Google Scholar] [CrossRef]
- Díaz-Montes, E.; Castro-Muñoz, R. Analyzing the Phenolic Enriched Fractions from Nixtamalization Wastewater (Nejayote) Fractionated in a Three-Step Membrane Process. Curr. Res. Food Sci. 2022, 5, 1–10. [Google Scholar] [CrossRef] [PubMed]
- White, T.J.; Bruns, T.; Lee, S.; Taylor, J. 38—Amplification and Direct Sequencing of Fungal Ribosomal RNA Genes for Phylogenetics. In PCR Protocols; Innis, M.A., Gelfand, D.H., Sninsky, J.J., White, T.J., Eds.; Academic Press: San Diego, CA, USA, 1990; pp. 315–322. ISBN 978-0-12-372180-8. [Google Scholar]
- Secretaría de Economía. Norma Mexicana NMX-AA-034-SCFI-2015. Análisis de Agua—Medición de Sólidos y Sales Disueltas En Aguas Naturales, Residuales y Residuales Tratadas—Método de Prueba. In Diario Oficial de la Federación; Dirección General de Normas: Ciudad de México, México, 2016. [Google Scholar]
- Latimer, G.W., Jr. Official Methods of Analysis of AOAC International, 20th ed.; AOAC International: Rockville, MD, USA, 2016. [Google Scholar]
- Rao, P.; Pattabiraman, T.N. Reevaluation of the Phenol-Sulfuric Acid Reaction for the Estimation of Hexoses and Pentoses. Anal. Biochem. 1989, 181, 18–22. [Google Scholar] [CrossRef]
- Bello Gil, D.; Carrera Bocourt, E.; Díaz Maqueira, Y. Determinación de Azúcares Reductores Totales En Jugos Mezclados de Caña de Azúcar Utilizando El Método Del Ácido 3,5 Dinitrosalicílico. ICIDCA 2006, XL, 45–50. [Google Scholar]
- Núñez, R.Á.; Pérez, B.R.; Chirinos, M. Contenido de azúcares totales, reductores y no reductores en Agave cocui Trelease. Multiciencias 2012, 12, 129–135. [Google Scholar]
- Worthington Worthington Enzyme Handbook. Enzymes, Enzymes Reagents and Related Biochemicals; Biochemical Corporation: Lakewood, NJ, USA, 1972. [Google Scholar]
- HACH Company. Nitrogen, Total, TNT, 10–150 Mg/L. Persulfate Digestion Method. Method 10072; HACH Company: Loveland, CO, USA, 2015. [Google Scholar]
- Pereira, A.P.; Mendes-Ferreira, A.; Estevinho, L.M.; Mendes-Faia, A. Mead Production: Fermentative Performance of Yeasts Entrapped in Different Concentrations of Alginate. J. Inst. Brew. 2014, 120, 575–580. [Google Scholar] [CrossRef]
- HACH Company. Método de Phosver 3 (Ortofosfatos). Método 8048. In Manual de Analisis de Agua; HACH Company: Loveland, CO, USA, 2000; pp. 851–855. [Google Scholar]
- HACH Company. Demanda Química de Oxígeno. Método 8000. In Manual de Analisis de Agua; HACH Company: Loveland, CO, USA, 2000; pp. 182–189. [Google Scholar]
- HACH Company. Organic Carbon, Total. Method 10129. In Manual de Analisis de Agua; HACH Company: Loveland, CO, USA, 2014. [Google Scholar]
- HACH Company. Hardness (Total & Calcium) Test Kit, HA-4P (145700); HACH Company: Loveland, CO, USA, 2019. [Google Scholar]
- Díaz-Montes, E.; Castro-Muñoz, R.; Yáñez-Fernández, J. An Overview of Nejayote, a Nixtamalization by Product. Ing. Agrícola Biosist. 2016, 8, 41–60. [Google Scholar] [CrossRef]
- Nogueira-Terrones, H.; Herman-Lara, E.; García-Alvardo, M.A.; Monroy-Rivera, J.A. Drying Kinetics and Sorption Isotherms of the Nejayote. Dry. Technol. 2004, 22, 2173–2182. [Google Scholar] [CrossRef]
- Maya-Cortés, D.C.; Figueroa Cárdenas, J.D.D.; Garnica-Romo, M.G.; Cuevas-Villanueva, R.A.; Cortés-Martínez, R.; Véles-Medina, J.J.; Martínez-Flores, H.E. Whole-Grain Corn Tortilla Prepared Using an Ecological Nixtamalisation Process and Its Impact on the Nutritional Value. Int. J. Food Sci. Technol. 2010, 45, 23–28. [Google Scholar] [CrossRef]
- Rojas-Candelas, L.E.; Diaz-Ramirez, M.; Gonzalez-Vazquez, N.; Rayas-Amor, A.A.; Cruz-Monterrosa, R.G.; Leon-Espinosa, E.B.; Villanueva-Carvajal, A. Physicochemical Characterization and Antioxidant Capacity of Popcorn Nejayote. Food Res. 2023, 7, 12–20. [Google Scholar] [CrossRef] [PubMed]
- Campechano Carrera, E.M.; de Dios Figueroa Cárdenas, J.; Arámbula Villa, G.; Martínez Flores, H.E.; Jiménez Sandoval, S.J.; Luna Bárcenas, J.G. New Ecological Nixtamalisation Process for Tortilla Production and Its Impact on the Chemical Properties of Whole Corn Flour and Wastewater Effluents. Int. J. Food Sci. Technol. 2012, 47, 564–571. [Google Scholar] [CrossRef]
- Castañeda-Ruelas, G.M.; Ibarra-Medina, R.K.; Niño-Medina, G.; Mora-Rochín, S.; Montes-Ávila, J.; Cuevas-Rodríguez, E.O.; Jiménez-Edeza, M. Phenolic Extract from Nejayote Flour: Bioactive Properties and Its Potential Use as an Antimicrobial Agent of Alginate-Based Edible Coatings. Cereal Chem. 2021, 98, 1165–1174. [Google Scholar] [CrossRef]
- López-Maldonado, E.A.; Oropeza-Guzmán, M.T.; Suárez-Meraz, K.A.; López-Maldonado, E.A.; Oropeza-Guzmán, M.T.; Suárez-Meraz, K.A. Integral Use of Nejayote: Characterization, New Strategies for Physicochemical Treatment and Recovery of Valuable by-Products. In Physico-Chemical Wastewater Treatment and Resource Recovery; IntechOpen: London, UK, 2017; ISBN 978-953-51-3130-4. [Google Scholar]
- Ramírez-Romero, G.; Reyes-Velazquez, M.; Cruz-Guerrero, A. Study of Nejayote as Culture Medium for Probiotics and Production of Bacteriocins. Rev. Mex. Ing. Quim. (RMIQ) 2013, 12, 463–471. [Google Scholar]
- Vacio-Muro, K.J.; Lozano-Álvarez, J.A.; Sánchez-González, M.N.; Vela, N.A.C.; Torres-Ramírez, E.; Jáuregui-Rincón, J. Remoción de contaminantes del nejayote con alginato y quitosano. Rev. Int. Contam. Ambient. 2020, 36, 497–515. [Google Scholar] [CrossRef]
- Trejo-Gonzalez, A.; Feria-Morales, A.; Wild-Altamirano, C. The Role of Lime in the Alkaline Treatment of Corn for Tortilla Preparation. In Modification of Proteins; Advances in Chemistry; American Chemical Society: Washington, DC, USA, 1982; Volume 198, pp. 245–263. ISBN 978-0-8412-0610-6. [Google Scholar]
- Méndez-Montealvo, G.; Solorza-Feria, J.; del Valle, M.V.; Gómez-Montiel, N.; Paredes-López, O.; Bello-Pérez, L.A. Composición química y caracterización calorimétrica de híbridos y variedades de maíz cultivadas en México. Agrociencia 2005, 39, 267–274. [Google Scholar]
- Chaidez-Laguna, L.D.; Torres-Chavez, P.; Ramírez-Wong, B.; Marquez-Ríos, E.; Islas-Rubio, A.R.; Carvajal-Millan, E. Corn Proteins Solubility Changes during Extrusion and Traditional Nixtamalization for Tortilla Processing: A Study Using Size Exclusion Chromatography. J. Cereal Sci. 2016, 69, 351–357. [Google Scholar] [CrossRef]
- Renk, J.S.; Burns, M.J.; Gilbert, A.M.; Anderson, N.; Waters, A.J.; Eickholt, D.P.; Kalambur, S.; Annor, G.A.; Hirsch, C.N. Variability in Changes of Acrylamide Precursors during Nixtamalization for Masa Production. LWT 2022, 161, 113400. [Google Scholar] [CrossRef]
- Tapia-Hernández, J.A.; Del-Toro-Sánchez, C.L.; Cinco-Moroyoqui, F.J.; Juárez-Onofre, J.E.; Ruiz-Cruz, S.; Carvajal-Millan, E.; López-Ahumada, G.A.; Castro-Enriquez, D.D.; Barreras-Urbina, C.G.; Rodríguez-Felix, F. Prolamins from Cereal By-Products: Classification, Extraction, Characterization and Its Applications in Micro- and Nanofabrication. Trends Food Sci. Technol. 2019, 90, 111–132. [Google Scholar] [CrossRef]
- Bell, S.-J.; Henschke, P.A. Implications of Nitrogen Nutrition for Grapes, Fermentation and Wine. Aust. J. Grape Wine Res. 2005, 11, 242–295. [Google Scholar] [CrossRef]
- Martínez-Flores, H.E.; Martíanez-Bustos, F.; Figueroa, J.D.C.; González-Hernández, J. Studies and Biological Assays in Corn Tortillas Made from Fresh Masa Prepared by Extrusion and Nixtamalization Processes. J. Food Sci. 2002, 67, 1196–1199. [Google Scholar] [CrossRef]
- Friedman, M. Lysinoalanine in Food and in Antimicrobial Proteins. In Impact of Processing on Food Safety; Jackson, L.S., Knize, M.G., Morgan, J.N., Eds.; Advances in Experimental Medicine and Biology; Springer: Boston, MA, USA, 1999; pp. 145–159. ISBN 978-1-4615-4853-9. [Google Scholar]
- Mamo, G.; Mattiasson, B. Alkaliphilic Microorganisms in Biotechnology. In Biotechnology of Extremophiles: Advances and Challenges; Rampelotto, P.H., Ed.; Grand Challenges in Biology and Biotechnology; Springer International Publishing: Cham, Switzerland, 2016; pp. 243–272. ISBN 978-3-319-13521-2. [Google Scholar]
- Kanekar, P.P.; Kanekar, S.P. Alkaliphilic, Alkalitolerant Microorganisms. In Diversity and Biotechnology of Extremophilic Microorganisms from India; Kanekar, P.P., Kanekar, S.P., Eds.; Microorganisms for Sustainability; Springer Nature: Singapore, 2022; pp. 71–116. ISBN 978-981-19157-3-4. [Google Scholar]
- Sanchez-Gonzalez, M.; Blanco-Gamez, A.; Escalante, A.; Valladares, A.G.; Olvera, C.; Parra, R. Isolation and Characterization of New Facultative Alkaliphilic Bacillus flexus Strains from Maize Processing Waste Water (Nejayote). Lett. Appl. Microbiol. 2011, 52, 413–419. [Google Scholar] [CrossRef] [PubMed]
- Kimani, B.G.; Kerekes, E.B.; Szebenyi, C.; Krisch, J.; Vágvölgyi, C.; Papp, T.; Takó, M. In Vitro Activity of Selected Phenolic Compounds against Planktonic and Biofilm Cells of Food-Contaminating Yeasts. Foods 2021, 10, 1652. [Google Scholar] [CrossRef] [PubMed]
- Guamán-Burneo, C.; Carvajal-Barriga, J. Caracterización e identificación de aislados de levaduras carotenogénicas de varias zonas naturales del Ecuador. Univ. Sci. 2009, 14, 187–197. [Google Scholar] [CrossRef]
- Li, Z.; Li, C.; Cheng, P.; Yu, G. Rhodotorula mucilaginosa—Alternative Sources of Natural Carotenoids, Lipids, and Enzymes for Industrial Use. Heliyon 2022, 8, e11505. [Google Scholar] [CrossRef]
- Cheng, Y.-T.; Yang, C.-F. Using Strain Rhodotorula mucilaginosa to Produce Carotenoids Using Food Wastes. J. Taiwan. Inst. Chem. Eng. 2016, 61, 270–275. [Google Scholar] [CrossRef]
- Aksu, Z.; Eren, A.T. Carotenoids Production by the Yeast Rhodotorula mucilaginosa: Use of Agricultural Wastes as a Carbon Source. Process Biochem. 2005, 40, 2985–2991. [Google Scholar] [CrossRef]
- Pereira, R.N.; da Silveira, J.M.; Burkert, J.F.d.M.; Ores, J.d.C.; Burkert, C.A.V. Simultaneour Lipid and Carotenoid Production by Stepwise Fed-Batch Cultivation of Rhodotorula mucilaginosa with Crude Glycerol. Braz. J. Chem. Eng. 2019, 36, 1099–1108. [Google Scholar] [CrossRef]
- Jarboui, R.; Baati, H.; Fetoui, F.; Gargouri, A.; Gharsallah, N.; Ammar, E. Yeast Performance in Wastewater Treatment: Case Study of Rhodotorula mucilaginosa. Environ. Technol. Rev. 2012, 33, 951–960. [Google Scholar] [CrossRef]
- Ertuğrul, S.; San, N.O.; Dönmez, G. Treatment of Dye (Remazol Blue) and Heavy Metals Using Yeast Cells with the Purpose of Managing Polluted Textile Wastewaters. Ecol. Eng. 2009, 35, 128–134. [Google Scholar] [CrossRef]
- Aibeche, C.; Selami, N.; Zitouni-Haouar, F.E.-H.; Oeunzar, K.; Addou, A.; Kaid-Harche, M.; Djabeur, A. Bioremediation Potential and Lead Removal Capacity of Heavy Metal-Tolerant Yeasts Isolated from Dayet Oum Ghellaz Lake Water (Northwest of Algeria). Int. Microbiol. 2022, 25, 61–73. [Google Scholar] [CrossRef]
- Angeles de Paz, G.; Martínez-Gutierrez, H.; Ramírez-Granillo, A.; López-Villegas, E.O.; Medina-Canales, M.G.; Rodríguez-Tovar, A.V. Rhodotorula mucilaginosa YR29 Is Able to Accumulate Pb2+ in Vacuoles: A Yeast with Bioremediation Potential. World J. Microbiol. Biotechnol. 2023, 39, 238. [Google Scholar] [CrossRef]
- Grujić, S.; Vasić, S.; Radojević, I.; Čomić, L.; Ostojić, A. Comparison of the Rhodotorula mucilaginosa Biofilm and Planktonic Culture on Heavy Metal Susceptibility and Removal Potential. Water Air Soil. Pollut. 2017, 228, 73. [Google Scholar] [CrossRef]
- Tuon, F.F.; Costa, S.F. Infección Por Rhodotorula. Revisión de 128 Casos. Rev. Iberoam. Micol. 2008, 25, 135–140. [Google Scholar] [CrossRef]
- Welthagen, J.J.; Viljoen, B.C. The Isolation and Identification of Yeasts Obtained during the Manufacture and Ripening of Cheddar Cheese. Food Microbiol. 1999, 16, 63–73. [Google Scholar] [CrossRef]
- Kot, A.M.; Błażejak, S.; Kieliszek, M.; Gientka, I.; Bryś, J. Simultaneous Production of Lipids and Carotenoids by the Red Yeast Rhodotorula from Waste Glycerol Fraction and Potato Wastewater. Appl. Biochem. Biotechnol. 2019, 189, 589–607. [Google Scholar] [CrossRef]
- Moran-Mejía, A.F.; Guillén-Garcés, R.A.; Moeller-Chávez, G.E.; Hernández-Romano, J.; Chávez-Béjar, M.I.; Olvera-Carranza, C.; Treviño-Quintanilla, L.G. Potencial de La Levadura Oleaginosa Clavispora lusitaniae Hi2 En La Conversión de Residuos Agroindustriales a Lípidos. Rev. Iberoam. Micol. 2022, 39, 6–15. [Google Scholar] [CrossRef]
- Prabhu, A.A.; Gadela, R.; Bharali, B.; Deshavath, N.N.; Dasu, V.V. Development of High Biomass and Lipid Yielding Medium for Newly Isolated Rhodotorula mucilaginosa. Fuel 2019, 239, 874–885. [Google Scholar] [CrossRef]
- Potumarthi, R.; Subhakar, C.; Vanajakshi, J.; Jetty, A. Effect of Aeration and Agitation Regimes on Lipase Production by Newly Isolated Rhodotorula mucilaginosa–MTCC 8737 in Stirred Tank Reactor Using Molasses as Sole Production Medium. Appl Biochem Biotechnol. 2008, 151, 700–710. [Google Scholar] [CrossRef]
- Liang, C.-M.; Yang, C.-F.; Du, J.-S. Lipid Production and Waste Reutilization Combination Using Yeast Isolate Rhodotorula mucilaginosa LP-2. Bioenerg. Res. 2021, 14, 1184–1195. [Google Scholar] [CrossRef]
- Díaz-Vázquez, D.; Orozco-Nunnelly, D.A.; Yebra-Montes, C.; Senés-Guerrero, C.; Gradilla-Hernández, M.S. Using Yeast Cultures to Valorize Tequila Vinasse Waste: An Example of a Circular Bioeconomy Approach in the Agro-Industrial Sector. Biomass Bioenergy 2022, 161, 106471. [Google Scholar] [CrossRef]
- Machado, W.R.C.; Murari, C.S.; Duarte, A.L.F.; Del Bianchi, V.L. Optimization of Agro-Industrial Coproducts (Molasses and Cassava Wastewater) for the Simultaneous Production of Lipids and Carotenoids by Rhodotorula mucilaginosa. Biocatal. Agric. Biotechnol. 2022, 42, 102342. [Google Scholar] [CrossRef]
- Sundaramahalingam, M.A.; Sivashanmugam, P. Concomitant Strategy of Wastewater Treatment and Biodiesel Production Using Innate Yeast Cell (Rhodotorula mucilaginosa) from Food Industry Sewerage and Its Energy System Analysis. Renew. Energy 2023, 208, 52–62. [Google Scholar] [CrossRef]

| Value | Reported Values | References | |
|---|---|---|---|
| pH | 10.3 ± 0.1 | 8–14 | [5,7,9,10,23] |
| Moisture (%) | 97.98 | 96–98 | [43,44] |
| Crude protein (%) * | 6.93 | 2.9–8 | [44,45,46,47] |
| Ether extract (%) * | 5.44 | 0.12–6.47 | [45,46,47,48] |
| Ash (%) * | 16.34 ± 0.1 | 0.767–31.2 | [8,45,47] |
| Nitrogen-free extract (%) * | 71.29 | 24.4–76 | [14,44,47] |
| Total solids (mg L−1) | 26,128 ± 24 | 11,680–46,523 | [7,8,10,20,43,49] |
| Total volatile solids (mg L−1) | 19,349.5 ± 135.5 | 19,293.3 | [21] |
| Total sugars (mg L−1) | 24,950 ± 125 | 23,570–63,410 | [50] |
| Reducing sugars (mg L−1) | 147.5 ± 0.62 | 149–818 | [21,50,51] |
| Glucose (mg L−1) | 81.0 ± 5.0 | ||
| Phosphorus (mg PO43− L−1) | 0.739 ± 0.001 | 7.6–190 | [7,9,18,20] |
| Total nitrogen (mg L−1) | 591.48 ± 5.68 | 120–440 | [7,9,18,20,21,26,49] |
| Assimilable nitrogen (mg L−1) | 112.0 ± 1.0 | ||
| Calcium hardness (mg L−1) | 2622 ± 152 | ||
| Magnesium hardness (mg L−1) | 570 ± 152 | ||
| Total hardness (mg CaCO3 L−1) | 3192.0 ± 152 | 1340–4000 | [5,7,8,9] |
| Chemical oxygen demand (COD) (mg L−1) | 27,400 ± 125 | 2500–68,000 | [5,8,9] |
| Total organic carbon (TOC) (mg L−1) | 26,584.05 ± 105.79 | 2984–9836 | [10,49] |
| Identification Key | Source | Microorganism | Growth | COD Removal Efficiency (%) | Colonial Morphology |
|---|---|---|---|---|---|
| OM-97 | Sewage | Bacterium | + | 35.24 | Yellow colony; greasy aspect, irregular edges. |
| LCRE | Sewage | Yeast | + | 75.11 | Pink colony; bright, wavy, and punctiform surface. |
| LC-98B | Sewage | Bacterium | + | 34.31 | Yellow colony; bright, punctiform surface. |
| B-16B | Sewage | Bacterium | + | 42.65 | White colony; bright, punctiform surface. |
| A-201 | Sewage | Bacterium | + | 48.22 | White colony; bright, coarse, flat surface. |
| E-31H | Contaminated soil | Fungus | + | 48.22 | Tall white filamentous fungus; green center. |
| GJ-25H | Contaminated soil | Fungus | + | 51.93 | Black fungus; cottony appearance. |
| E-31B | Contaminated soil | Bacterium | + | 32.08 | Yellow colony; punctiform, matte surface. |
| GJ-25B | Contaminated soil | Bacterium | + | 39.57 | Pink colony; punctiform, flat surface. |
| MR1 | Culture collection | Yeast | + | 32.17 | Pink colony; bright, circular, convex surface. |
| MR2 | Culture collection | Bacterium | + | 45.21 | White colony; elevated around the entire edge. |
| MR3 | Culture collection | Bacterium | − | – | White colony; elevated around the entire edge. |
| MR4 | Culture collection | Bacterium | + | 32.69 | Beige colony; elevated around the entire edge, convex surface. |
| MR5 | Culture collection | Bacterium | − | – | White colony; smooth surface around the edge. |
| MR6 | Culture collection | Bacterium | + | 41.03 | White colony; wavy around the edge. |
| Strain | Substrate | Initial pH | Final pH | COD0 (g L−1) | COD Removal Efficiency (%) | Time (Days) | Final Product | Reference |
|---|---|---|---|---|---|---|---|---|
| R. mucilaginosa | Olive oil mill wastewater | 5.52 | 7.82 | 26.7 | 38.8 | 6 | NS | [69] |
| R. mucilaginosa F-1 | Waste ketchup | 3.32 | ND | 20.0 | 84 | 9 | Carotenoids | [66] |
| R. mucilaginosa ATCC 66034 | Potato wastewater | 12 | 9.5 | 30.82 | 49 | 5 | Lipids and carotenoids | [76] |
| R. mucilaginosa LP-2 | Crude glycerol | 6 | 6.19 | 1533 | 54.6 | 9 | Lipids | [80] |
| R. mucilaginosa LP-2 | Sugarcane molasses | 5.8 | 7 | 1230 | 52.3 | 9 | Lipids | [80] |
| R. mucilaginosa ATCC 9450 | Tequila vinasse waste | 3.75 | ND | 43.93 | 20 | 2 | Animal feed supplement | [81] |
| R. mucilaginosa URM7509 | Sugarcane molasses + cassava wastewater | 5.8 | 7.0 | 35.33 | 82.9 | 7 | Lipids and carotenoids | [82] |
| R. mucilaginosa SML | Food flavoring wastewater + glucose | 6.6 | 6.8 | 2.69 | 99.8 | 2.83 | Biodiesel | [83] |
| R. mucilaginosa LCRE | Nejayote | 10.3 | 7.84 | 27.4 | 75.5 | 12 | NS | This work |
| Condition | Reactor/ Mode of Operation | Initial pH | Final pH | COD0 (g L−1) | COD Removal Efficiency (%) | Time (Days) | Supplementation | Microorganism | Product | Reference |
|---|---|---|---|---|---|---|---|---|---|---|
| Aerobic | Rotating biological reactor/continuous | 5.8 | 7.0 | 6.4 | 84.6 | 20 (HRT = 2.5 days) | None | Amylolytic, proteolytic, and lipolytic bacteria (genera were not specified) | Biomass for livestock feed | [19] |
| Aerobic | Cascade bubble reactor/batch | 6 | 7.9 | 26.5–28.0 | 86.4 | 36 | Supplemented with KH2PO4 and (NH4)2SO4 | Paenibacillus amylolyticus, Pseudomonas putida, and Acinetobacter sp. | Biomass | [7] |
| Aerobic | Flask/batch | 8–10 | NR | 6.44 | 75 | 15 | 90% nejayote 10% swine pork wastewater | Chlorella vulgaris | Biomass | [18] |
| Aerobic | Flask/batch | 8–10 | NR | 6.44 | 76 | 15 | 90% nejayote 10% swine pork wastewater | Arthrospira maxima | Biomass | [18] |
| Aerobic | Flask/batch | 10.3 | 7.84 | 27.4 | 75.5 | 12 | None | Rhodotorula mucilaginosa | Biomass | This work |
| Anaerobic | APCR-UASB/CR | 9 | 7.45 | 22.85 | 96.5 | 30 (28.9 m3 m−2 d−1) | Nejayote | Native-mixed microbial consortium from deep soil, cattle manure, and pig manure (genera were not specified). | Methane | [20] |
| Anaerobic | MSB/batch | 5.5 | NR | 52.8 | 27.5 | 5–5.8 | 80% tequila vinasses 20% nejayote | A mixed culture in which the main bacteria were Acetobacter orientalis, Lactobacillus casei, Clostridium beijerinckii, Acetobacter lovaniensis, and Sporolactobacillus terrae | Biohydrogen | [21] |
| Anaerobic | Serum bottles/batch | 10.4 | 4.9 | 28,950 | 18.7 | 20 approx. | 60% Nejayote 40% Brewery wastewater | The predominant communities of bacteria were Clostridium and Burkholderia | Biohydrogen | [22] |
| Anaerobic | MSB/batch | 5.5 | 5.5 | NR | 47 | 0.5 | Nejayote Abattoir Wastewater, C/N ratio = 30 | Mixed culture, mainly consisting of Clostridium butyricum | Biohydrogen | [23] |
Disclaimer/Publisher’s Note: The statements, opinions and data contained in all publications are solely those of the individual author(s) and contributor(s) and not of MDPI and/or the editor(s). MDPI and/or the editor(s) disclaim responsibility for any injury to people or property resulting from any ideas, methods, instructions or products referred to in the content. |
© 2024 by the authors. Licensee MDPI, Basel, Switzerland. This article is an open access article distributed under the terms and conditions of the Creative Commons Attribution (CC BY) license (https://creativecommons.org/licenses/by/4.0/).
Share and Cite
Román-Escobedo, L.C.; Cristiani-Urbina, E.; Morales-Barrera, L. Bioremediation with an Alkali-Tolerant Yeast of Wastewater (Nejayote) Derived from the Nixtamalization of Maize. Fermentation 2024, 10, 219. https://doi.org/10.3390/fermentation10040219
Román-Escobedo LC, Cristiani-Urbina E, Morales-Barrera L. Bioremediation with an Alkali-Tolerant Yeast of Wastewater (Nejayote) Derived from the Nixtamalization of Maize. Fermentation. 2024; 10(4):219. https://doi.org/10.3390/fermentation10040219
Chicago/Turabian StyleRomán-Escobedo, Luis Carlos, Eliseo Cristiani-Urbina, and Liliana Morales-Barrera. 2024. "Bioremediation with an Alkali-Tolerant Yeast of Wastewater (Nejayote) Derived from the Nixtamalization of Maize" Fermentation 10, no. 4: 219. https://doi.org/10.3390/fermentation10040219
APA StyleRomán-Escobedo, L. C., Cristiani-Urbina, E., & Morales-Barrera, L. (2024). Bioremediation with an Alkali-Tolerant Yeast of Wastewater (Nejayote) Derived from the Nixtamalization of Maize. Fermentation, 10(4), 219. https://doi.org/10.3390/fermentation10040219

